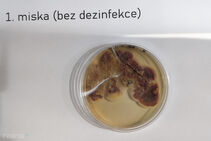
Miska 1.
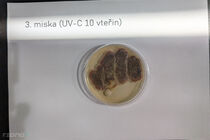
3. miska (UV-C, 10 vteřin)
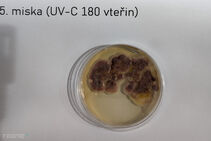
5. miska (UV-C, 180 vteřin)
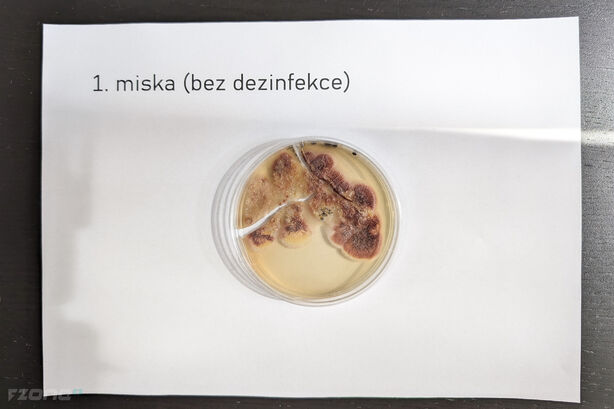
Miska 1.
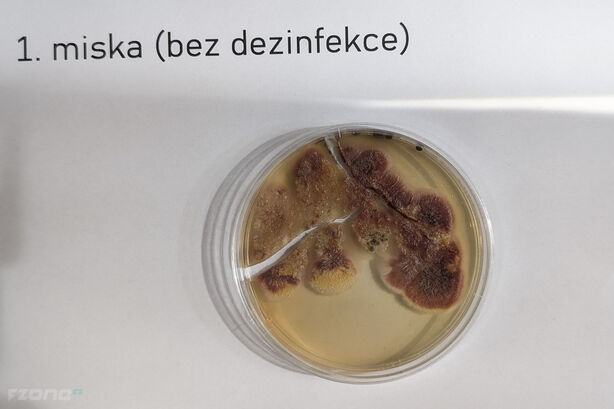
Miska 1.
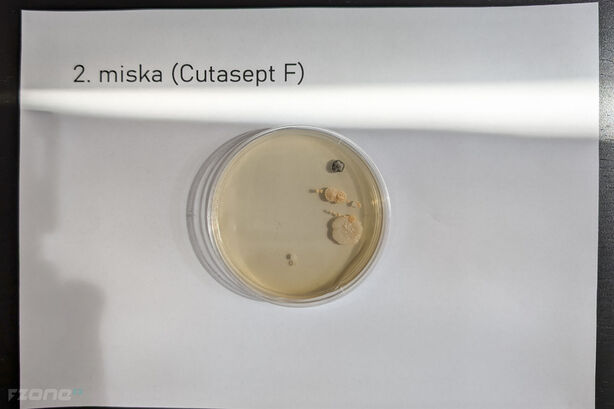
2. miska (Cutasept F)
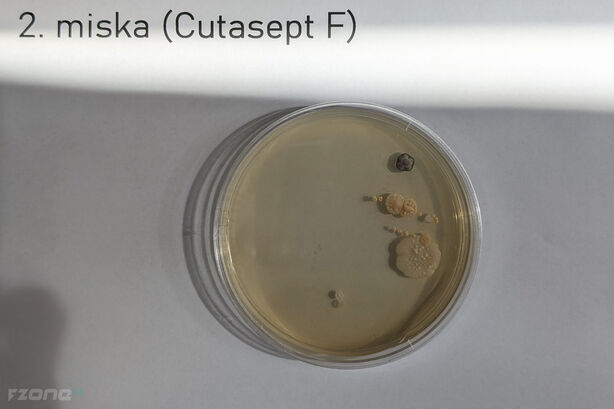
2. miska (Cutasept F)
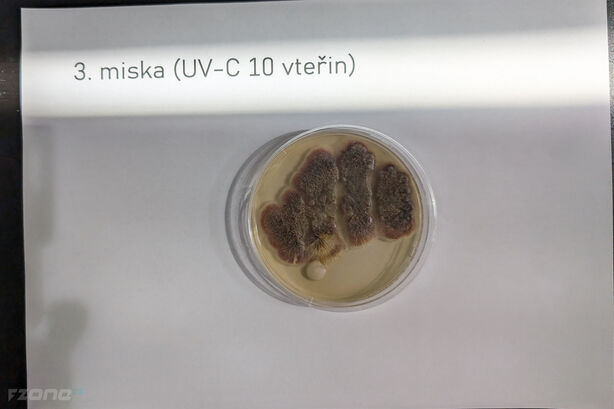
3. miska (UV-C, 10 vteřin)
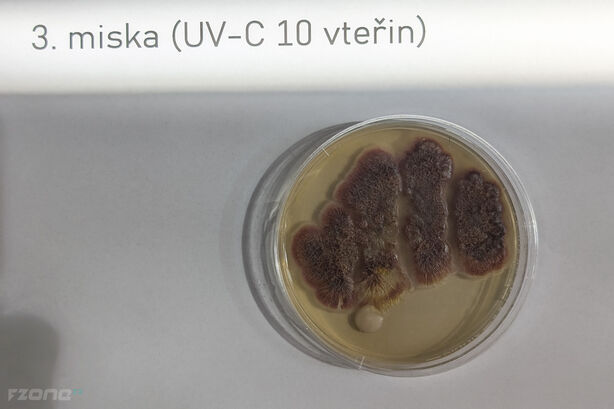
3. miska (UV-C, 10 vteřin)
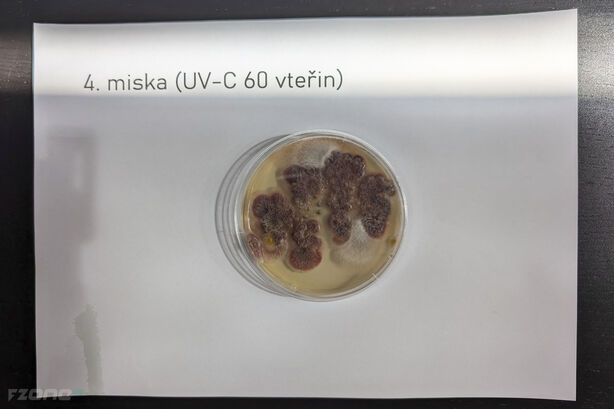
4. miska (UV-C, 60 vteřin)
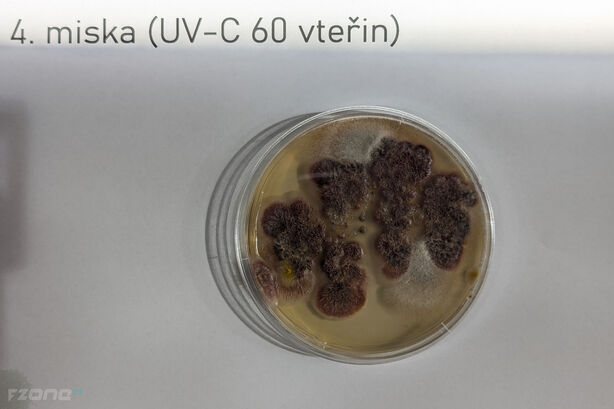
4. miska (UV-C, 60 vteřin)
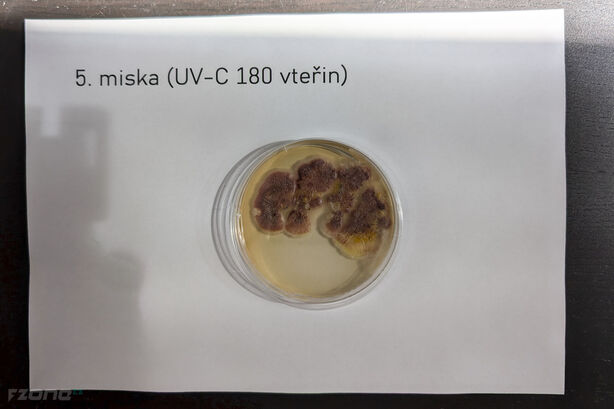
5. miska (UV-C, 180 vteřin)
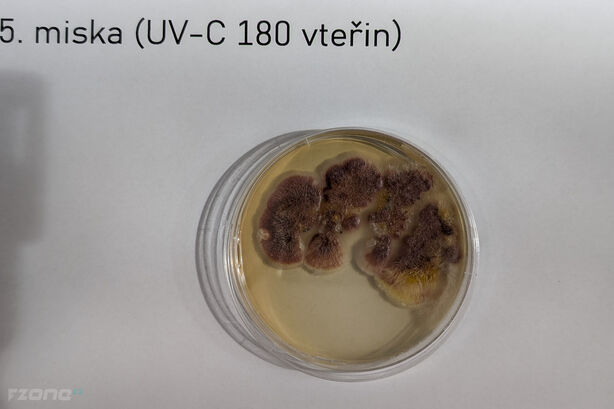
5. miska (UV-C, 180 vteřin)

Nejen v době pandemie COVID-19 se staly trendem, protože slibovaly rychlou sterilizaci, respektive dezinfekci všech možných povrchů a předmětů. Ano, mluvíme o UV-C lampách, které běžně pořídíte na internetu i dnes. Rozhodně nejde o hračku; UV-C světlo je pro lidi nebezpečné, ovšem při správném používání slibuje zázraky, alespoň co se eliminace mikroorganismů týká. Jak je tomu doopravdy? Vyzkoušeli jsme za vás...
Co je vlastně UV-C světlo?
Jedná se o jednu z kategorií ultrafialového záření, která má vlnovou délku v rozmezí přibližně 100 až 280 nanometrů. Na Zemi se UV-C záření přirozeně nevyskytuje ve velkém množství, protože je pohlcováno ozonovou vrstvou v atmosféře. Proto je jeho použití omezeno na speciální zařízení, která generují UV-C záření uměle. UV-C záření je nejenergetičtější a má schopnost ničit DNA a RNA mikroorganismů, což jej činí účinným v dezinfekci a sterilizaci. Nejde o žádný mýtus; dezinfekce pomocí UV-C světla se běžně používá například v nemocnicích, kde jsou nároky na dezinfekci zřejmě nejvyšší.
V praxi se používá například v zařízeních na dezinfekci vzduchu, vody nebo povrchů. Je však nebezpečné pro lidskou kůži a oči, a proto se při používání UV-C záření musí dbát na bezpečnost – takovou lampou nikdy nemíříme na sebe, ale ani na jiného člověka. Ideální ochranou jsou speciální brýle, které UV-C světlo blokují.
Ultrafialové (UV) záření je rozděleno do tří hlavních kategorií podle vlnové délky: UV-A, UV-B a UV-C. Každý z těchto typů má různé vlastnosti, účinky a použití:
- UV-A (320–400 nm): UV-A má nejdelší vlnovou délku a tvoří přibližně 95 % ultrafialového záření, které dopadá na zemský povrch. UV-A záření proniká hluboko do pokožky a je hlavní příčinou předčasného stárnutí kůže (fotostárnutí) a vzniku vrásek. Je také spojováno s některými formami rakoviny kůže, ale jeho schopnost přímo poškozovat DNA je nižší než u UV-B. UV-A záření se používá v soláriích a při léčbě některých kožních onemocnění (např. fototerapie).
- UV-B (280–320 nm): UV-B záření má kratší vlnovou délku než UV-A a tvoří zhruba 5 % ultrafialového záření, které dopadá na zemský povrch. Větší část je absorbována ozonovou vrstvou. UV-B je hlavní příčinou spálení pokožky (solární erytém) a hraje klíčovou roli při vzniku rakoviny kůže, protože může přímo poškozovat DNA v kožních buňkách. Je také zodpovědné za syntézu vitamínu D v kůži.
- UV-C (100–280 nm): UV-C záření má nejkratší vlnovou délku a je nejenergetičtější. Prakticky veškeré UV-C záření z vesmíru je absorbováno ozonovou vrstvou a atmosférou, takže přirozeně na zemský povrch nedopadá. UV-C záření je velmi nebezpečné a může způsobit vážné poškození DNA, což vede k rychlému zabíjení mikroorganismů. Z tohoto důvodu se používá k dezinfekci a sterilizaci, ale je také škodlivé pro lidskou kůži a oči.
Jak jsme testovali?
Abychom zajistili identické podmínky, testovali jsme ve stejný den. Pro zajištění stejných podmínek jsme obstarali Petriho misky se sterilním agarem, který je živnou půdou pro vše, co jsme se rozhodli do misek „nasadit“. Celkem jsme pořídili pětici misek, přičemž do každé jsme „obtiskli“ ruku po hodinovém úklidu všech povrchů v koupelně, samozřejmě bez rukavic. Postup byl následující:
- 1. miska: bez dezinfekce
- 2. miska: s použitím dezinfekce (Cutasept F)
- 3. miska: bez dezinfekce, 10 vteřin plynulého ozařování pomocí UV-C lampy 59S X5 ze vzdálenosti 2,5 cm
- 4. miska: bez dezinfekce, 60 vteřin plynulého ozařování pomocí UV-C lampy 59S X5 ze vzdálenosti 2,5 cm
- 5. miska: bez dezinfekce, 180 vteřin plynulého ozařování pomocí UV-C lampy 59S X5 ze vzdálenosti 2,5 cm
Co se týká použití sterilizační lampy, vycházeli jsme z návodu výrobce. V tomto případě jsme využili skládací sterilizační lampu 59S X5, která je díky svým rozměrům a bateriovému provozu ideální i na cesty. Pro zajištění sterilizace povrchu je dle slov výrobce nutné minimálně 5× až 10× plynule „přejet“ po dané části povrchu, který chcete sterilizovat, a to ideálně z malé vzdálenosti, zhruba 2,5 centimetru. Je jasné, že sterilizace takového polštáře zabere mnohem delší dobu než třeba sterilizace povrchu mobilního telefonu. I proto jsme se neorientovali podle počtu přejetí, ale podle času. Vzhledem k malým rozměrům Petriho misky byla sterilizace opravdu důkladná; za 10 vteřin jsme stihli misku „přejet“ celkem 10×, ve zbylých úsecích šlo o násobky, minimální požadavky jsme tedy s přehledem splnili i u nejkratšího časového úseku.
Dezinfekce proběhla bezprostředně po kontaminaci agaru, tedy postupně, ne hromadně. Všechny misky jsme na začátku testování samozřejmě důkladně označili. Misky byly umístěny při pokojové teplotě s průměrem 27 stupňů Celsia.
| Upozornění: Přestože je UV-C světlo díky své vlnové délce velice účinné, nedokáže proniknout hluboko do materiálů, tedy ani agaru. Proto byl „obtisk ruky“ pouze letmý a ihned poté byl povrch agaru ošetřen UV-C světlem, bez prodlevy. Dezinfekce typu Cutasept F (sprej) dokáže proniknout díky kapalné podobě hlouběji, ale i tak ne dostatečně hluboko všemi vrstvami agaru. Výchozí stav byl tedy pro oba pokusy rovnocenný. |
Předpoklady
Předpokladem bylo, že Petriho miska s agarem bez umytí rukou a použití jakékoliv dezinfekce bude po třech dnech kompletně osídlena mikroorganismy a plísněmi. U druhé misky, která byla ošetřena dezinfekcí, jsme předpokládali, že růst všech mikroorganismů nebude žádný nebo minimální. U zbylých tří misek jsme očekávali, že se minimálně vyrovnají dezinfekci, protože účinky UV-C světla jsou nesporné.
Výsledky testování
Výsledky testování jsme zkontrolovali za 48 hodin po kontaminaci misek.
1. miska (bez jakékoliv dezinfekce)

2. miska (Cutasept F)


3. miska (UV-C, 10 vteřin)

4. miska (UV-C, 60 vteřin)


5. miska (UV-C, 180 vteřin)

Zhodnocení a závěr
Z dnešního testu vyplývá, že ozařování UV-C světlem nebylo účinné, a to ani v nejdelším časovém úseku 180 vteřin. Výrazně lepších výsledků jsme dosáhli s běžně dostupnou dezinfekcí – i když ani zde nedošlo ke kompletní dezinfekci, výsledky jsou zdaleka nejlepší.
Co z dnešního testu vyplývá? UV-C světlo v přenosné lampě 59S X5 není dostatečně silné a byla by třeba delší expozice, případně nefunguje vůbec. Pokud si každopádně podobnou UV-C lampu berete například na dovolenou s vidinou snadné sterilizace povrchů a předmětů, například lůžkovin, nádobí a povrchů v koupelně, krátká expozice není zárukou toho, že jste zahubili veškeré mikroorganismy – určitě ne 99 %, jak slibuje výrobce. V dalším pokračování délku expozice prodloužíme a doplníme jej dalším produktem, který slibuje sterilizaci předmětů pomocí UV-C světla.

zajímalo by mne, jak je účinná desinfekce ozónem? Existuje na tuto desinfekci nějaká obdobná srovnávací studie, na jejímž základě by se dala vyhodnotit účinost?
Jedná se mi o bakteriální a covidové kontaminace. Jaroslav Tošil
Za prve, nevhodny puvodni vzorek, uz zaklad to ze obtiskne nekdo svoji ruku.
Za druhe pouziti, 1 misky na experiment. Spravne se pouziva min. 3 opakovani, ktera jsou nezavisla a nejsou technickymi replikaty.
Za treti, ocividne jde o plisen, ev. kavasinku a ne napr bakterii, ktera muze nebo nemusi pochazet z onech rukou.
Za ctvrte, vyhodnocovaci technika je nedostatecna. Chybi, pocet a charakterizace, napr. miska 3 ma mozna 4 kolonie mozna 5.
Za pate, z dnesniho experimentu nic nevyplyva jelikoz je extreme nevedecky.
Nicmene na dovolenou bych mozna doporucil radci rucni parni cistic.